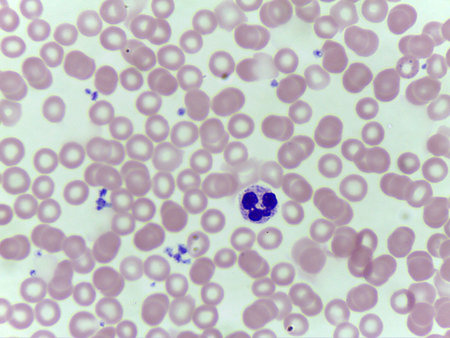
Blood smear showing white and red blood cellsの写真素材

写真素材 - Blood smear showing white and red blood cells
キーワード
- analysis
- biochemistry
- biology
- biologylab
- blood
- bloodcells
- cell
- cellcount
- cellstructure
- cellular
- clinical
- cytoplasm
- diagnostic
- education
- erythrocyte
- examination
- health
- healthcare
- hematology
- hematologyanalysis
- hemoglobin
- human
- identification
- laboratory
- laboratorytest
- leukocyte
- magnified
- medical
- medicalimage
- micrograph
- microscope
- microscopefield
- microscopeimage
- microscopeview
- microscopy
- monolayer
- morphology
- neutrophil
- nucleated
- nucleus
- pathology
- plasma
- research
- researchstudy
- sample
- scientific
- slide
- smear
- specimen
- stained
- test
- thinfilm
類似作品
Blood test
blood smear is ...
microscope lens...
sample for bloo...
blood smear is ...
Medical laborat...
Red cells Bacte...
Photography of ...
Polycythemia ve...
Woman in a labo...
blast cells
Glass dropper a...
Splashes and st...
blurry image of...
Workspace. Brus...
Creative ebru a...
cosmetic cream ...
Medical equipme...
blood grouping ...
Study of Hepati...
Blood smear of ...
Wax blurs in wa...
Cosmetic smear ...
Top view of blo...
blood films for...
Surface of Prin...
Blood sampling ...
partial view of...
Microscopic Vie...
Glass medical a...
Blood sample
Scientist holdi...
Blood test.
blood testing i...
Blue bacteria c...
Female scientis...
Smears of trans...
Macro photo ana...
Scientist exami...
scientist weari...
Woman holding s...
Smear of Gram's...
Blood Sugar Tes...
Female scientis...
Rows of microsc...
Pseudothrombocy...
flower macro ph...
blood splashed ...
Bloody spotted ...